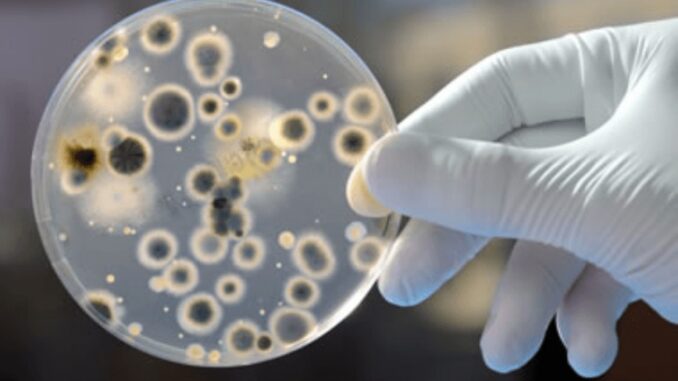

Autoridades reforçam medidas para conter disseminação da infecção.
Por Paloma de Sá |GNEWSUSA
O Hospital do Servidor Público Estadual (HSPE), localizado na zona sul de São Paulo, enfrenta um surto do superfungo Candida auris, com 15 casos registrados desde o início de janeiro de 2025. Destes, 14 foram identificados como colonizações — quando o fungo está presente no organismo sem causar infecção — e um paciente foi infectado, vindo a óbito posteriormente. No entanto, segundo a instituição, a morte foi resultado de complicações cirúrgicas, e não diretamente da infecção fúngica.
O Candida auris é um fungo emergente e altamente resistente a medicamentos, sendo motivo de preocupação global devido à sua capacidade de causar infecções invasivas e surtos hospitalares. Ele pode sobreviver por longos períodos em superfícies inanimadas, como roupas de cama, corrimões e equipamentos médicos, aumentando o risco de transmissão.
Medidas de controle e risco para pacientes
Diante do surto, o hospital adotou medidas rigorosas para evitar a propagação do fungo, incluindo:
-
Isolamento de pacientes em quartos individuais;
-
Intensificação dos protocolos de higienização;
-
Monitoramento e coletas frequentes para detecção precoce;
-
Treinamentos específicos para profissionais de saúde.
Pacientes imunocomprometidos, em uso de antibióticos, que passaram por quimioterapia ou transplantes, além daqueles internados em Unidades de Terapia Intensiva (UTI), estão no grupo de maior risco para infecções graves. Os sintomas podem incluir febre persistente, calafrios e deterioração clínica sem resposta a antibióticos comuns.
Acompanhamento e perspectivas
O HSPE informou que está trabalhando em conjunto com a Agência Nacional de Vigilância Sanitária (Anvisa) e demais órgãos de saúde para monitorar e controlar a situação. Reuniões semanais estão sendo realizadas para avaliar a efetividade das ações e a necessidade de novas medidas.
O Candida auris representa um desafio significativo para a saúde pública global devido à sua resistência a tratamentos convencionais. A Sociedade Brasileira de Infectologia (SBI) reforça a importância da vigilância contínua e do uso adequado de antifúngicos alternativos para evitar a disseminação do patógeno.
A situação segue sendo monitorada pelas autoridades de saúde, e novas atualizações serão divulgadas conforme o avanço das investigações e das ações de controle.
- Leia mais:


Faça um comentário